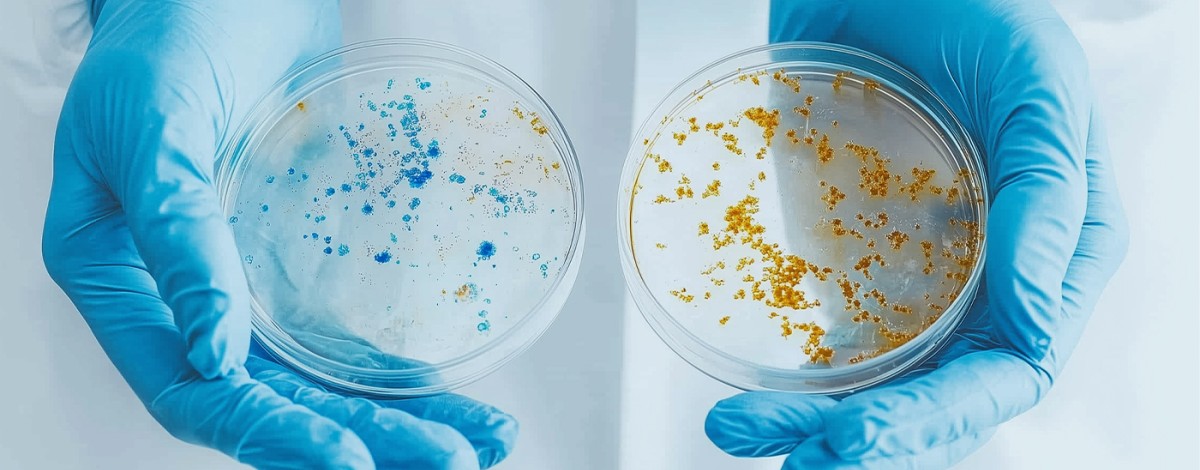

Institut Dr. Nuss
Cutting-edge chemical and microbiological testing, backed by DAkkS accreditation.
Institut Dr. Nuss specializes in chemical and microbiological environmental analysis, providing advisory services to both public and private institutions on hygiene management.
In our laboratories, we analyze water, soil, air, gases, food, feed, raw materials, and other substances for components and potentially harmful environmental or health-related contaminants. These analyses are conducted using the latest scientific and technological methods.
Our hygiene consulting services are delivered by trained hygiene specialists. We prioritize qualified analysis through a highly motivated team to ensure optimal customer advice and build long-term successful relationships.
As of March 23, 2020, the Institut Dr. Nuss GmbH & Co. KG has been granted an unlimited accreditation by the Deutsche Akkreditierungsstelle (DAkkS). This confirms the institute's competency in conducting tests in accordance with the updated DIN EN ISO/IEC 17025:2018 standards across its two locations.
Focus topics
- Environmental Analytics
- Soil and Water Testing
- Waste Management
- Air Quality Analysis
- Consulting Services
- Accredited Laboratory Services
location
Bad Kissingen, Germany
Partner since
Founding year
ISO number
Partner website

Our focuses:
Comprehensive Environmental Analytics
Institut Dr. Nuss is a leading firm in environmental analytics, offering a wide range of services aimed at ensuring environmental safety and compliance. Their expertise includes testing for soil, water, air quality, and waste management, providing reliable, certified results.
Specialized Soil and Groundwater Testing
One of the company’s core services is detailed soil and groundwater analysis. This service is crucial for industries like agriculture and construction, offering vital insights into environmental conditions that inform resource management and land use.
Advanced Waste and Air Quality Solutions
Institut Dr. Nuss specializes in waste management and air quality assessments. Their expert analysis helps businesses adhere to environmental regulations by offering sustainable waste disposal solutions and air pollution mitigation strategies.
Trusted Environmental Consulting
Alongside their analytical services, Institut Dr. Nuss offers consulting to help businesses meet environmental compliance requirements. Their advice on best practices ensures organizations operate sustainably while minimizing their ecological impact.